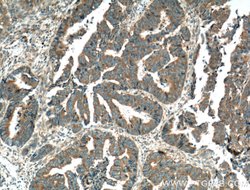
PTPN23 Rabbit anti-Human, Mouse, Rat, Polyclonal, Proteintech 150 &mu;L;
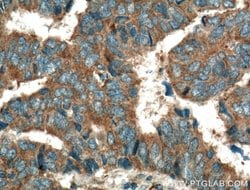
PTPN23 Rabbit anti-Human, Mouse, Rat, Polyclonal, Proteintech 150 &mu;L;

missing translation for 'onlineSavingsMsg'
Learn More
Learn More
PTPN23 Rabbit anti-Human, Mouse, Rat, Polyclonal, Proteintech
Rabbit Polyclonal Antibody
Brand: Proteintech 10472-1-AP-150UL
This item is not returnable.
View return policy
Description
Plays a role in sorting of endocytic ubiquitinated cargos into multivesicular bodies (MVBs) via its interaction with the ESCRT-I complex (endosomal sorting complex required for transport I), and possibly also other ESCRT complexes. May act as a negative regulator of Ras-mediated mitogenic activity. Plays a role in ciliogenesis.Specifications
| PTPN23 | |
| Polyclonal | |
| Unconjugated | |
| PTPN23 | |
| HD PTP, HDPTP, KIAA1471, PTP TD14, PTPN23 | |
| Rabbit | |
| Antigen Affinity Chromatography | |
| RUO | |
| 104831, 117552, 25930 | |
| -20°C | |
| Liquid |
| Immunocytochemistry, Immunofluorescence, Immunohistochemistry (Paraffin), Immunoprecipitation, Western Blot | |
| 0.38 mg/mL | |
| PBS with 50% glycerol and 0.1% sodium azide; pH 7.3 | |
| O88902, Q6PB44, Q9H3S7 | |
| Ptpn23 | |
| PTPN23 Fusion Protein Ag0765 | |
| 150 μL | |
| Primary | |
| Human, Mouse, Rat | |
| Antibody | |
| IgG |
Product Content Correction
Your input is important to us. Please complete this form to provide feedback related to the content on this product.
Product Title
Spot an opportunity for improvement?Share a Content Correction